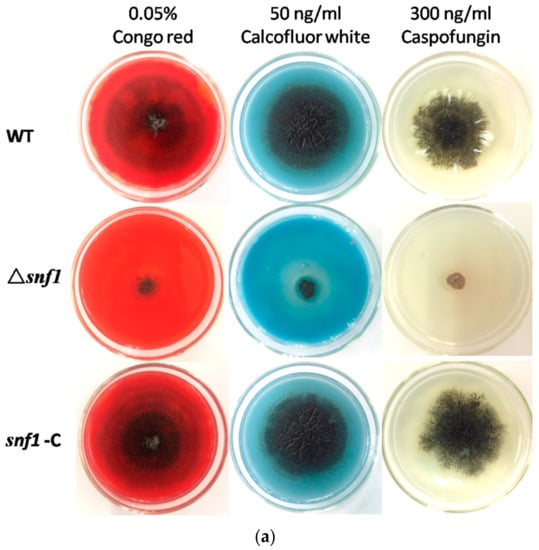

Abstract
Highly conserved, the Snf1/AMPK is a central regulator of carbon metabolism and energy production in the eukaryotes. However, its function in filamentous fungi has not been well established. In this study, we reported functional characterization of Snf1/AMPK in the growth, development and secondary metabolism in the filamentous fungus Pestalotiopsis microspora. By deletion of the yeast SNF1 homolog, we found that it regulated the utilization of carbon sources, e.g., sucrose, demonstrating a conserved function of this kinase in filamentous fungus. Importantly, several novel functions of SNF1 were unraveled. For instance, the deletion strain displayed remarkable retardation in vegetative growth and pigmentation and produced a diminished number of conidia, even in the presence of the primary carbon source glucose. Deletion of the gene caused damages in the cell wall as shown by its hypersensitivities to Calcofluor white and Congo red, suggesting a critical role of Snf1 in maintaining cell wall integrity. Furthermore, the mutant strain Δsnf1 was hypersensitive to stress, e.g., osmotic pressure (1 M sorbitol), drug G418 and heat shock, though the mechanism remains to be illustrated. Significantly, disruption of the gene altered the production of secondary metabolites. By high-performance liquid chromatography (HPLC) profiling, we found that Δsnf1 barely produced secondary metabolites, e.g., the known product pestalotiollide B. This study suggests that Snf1 is a key regulator in filamentous fungus Pestalotiopsis microspora concerting carbon metabolism and the filamentous growth, conidiation, cell wall integrity, stress tolerance and the biosynthesis of secondary metabolites.
1. Introduction
Adenosine monophosphate (AMP)-activated protein kinase (AMPK) is widely found in eukaryotic cells, which plays diverse, yet critical regulatory roles in the metabolism of nutrients such as sugar, fat and protein and thus concerts the response of the cell to environmental stress [1,2]. Many fungi have the homologs of AMPK, which is one of the subunits in a heterotrimeric protein consisting of one catalytic subunit—α subunit, known as SNF1 in yeast—and two regulatory subunits—β and γ subunits. Generally, upstream kinases, e.g., Sak1, Tos3 or Elm1, can activate SNF1 protein kinase through phosphorylation of the kinase domains at Thr210 [3,4,5,6,7]. The protein phosphatase complex (Reg1/Glc7), which responses to nutrient signals (such as high concentration of glucose) dephosphorylates SNF1 to inactivated its function [8]. In the baker’s yeast, SNF1 controls the transcription of a large set of genes that covers the cellular processes of carbon sources, gluconeogenesis, respiration, material transport and meiosis. Known as the gauge of energy, SNF1 is generally responsive to the in vivo ratio of adenosine triphosphate (ATP) to AMP to regulate carbon metabolism. SNF1 mutated strain cannot accumulate glycogen and the intracellular glucose-6-phosphate concentration decreases significantly [9,10,11]. On the other hand, SNF1 complex is one of the key regulators in the responsive processes to stress, e.g., SNF1 activates the heat shock transcription factor (HSF), stress-response transcription factor Msn2 and GATA transcription factor Gln3 [12,13,14,15,16,17]. The general function of the AMPK kinase family is largely conserved over the eukaryotic domains [16,17]. However, its role in filamentous fungi remains largely uncharacterized.
As a part of our efforts to the understanding of the regulation of secondary metabolism in Pestalotiopsis microspora, we identified a homolog of snf1 in the genome of P. microspora NK17. This strain was originally isolated as a producer of taxol-like molecules [18,19]. And an analog of a new class of cholesterol ester transfer protein inhibitor, pestalotiollide B (PB) was also produced by the fungus [20]. Through targeting disruption, we found that P. microspora snf1 gene was involved in carbon source metabolism and controlled the mycelial growth and development.
It played crucial roles in cell wall biosynthesis, drug resistance and osmotic stress tolerance. Some of the functions are divergent from the baker’s yeast. Our study opens an avenue to explore the function of AMPK in concerting the primary and the secondary metabolism in filamentous fungi.
2. Materials and Methods
2.1. Strains and Culture Conditions
P. microspora NK17, a taxol-producing strain was previously isolated by our laboratory [18]. Its uracil auxotrophic strain, Δura3-NK17, was used as the host for gene manipulation in this study. Unless otherwise specified, fungal strains were grown or maintained in PDA (20% potato, 1.0% dextrose and 1.5% agar) at 25–28 °C, or PDB (PDA without agar) with shaking at 180 rpm, 25–28 °C (MAXQ 6000, Thermo Scientific, Waltham, MA, USA).
2.2. Construction of snf1 Mutant and Complemented Strains
The technique, Agrobacterium tumefaciens-mediated genetic transformation of NK17, was previously described by Hao et al. [19]. To achieve the deletion of snf1 (Δsnf1), briefly, the deletion vector pOSCAR-URA-Snf1 was constructed through an OSCAR one-step protocol [21]. The selective marker was the gene pm-ura3 that restores the prototrophic phenotype of uracil biosynthesis. The homologous fragments for targeting of snf1 were obtained by polymerase chain reaction (PCR) amplification and gel-purified using the AxyPrep DNA Gel Extraction Kit (Axygen, Corning, NY, USA). Thereafter, pOSCAR-URA-Snf1 was delivered into A. tumefaciens LBA4404 by electroporation [22]. Then, A. tumefaciens carrying pOSCAR-URA-Snf1 was co-cultured with 107 conidia from Δura3-NK17 at 28 °C on IM plate (50 mgL−1 uracil and 40 mgL−1 acetosyringone) on a nitrocellulose filter. After 2-day incubation, the filter was transferred onto YNB plates supplied with 100 mgL−1 cefotaxime. Finally, individual fungal transformants were obtained through single-spore purification. All primers used in this study are listed in Table 1.
Table 1.
Primers used in this study.
For complementation, plasmid pOSCAR-Snf1C was constructed using the BP Clonase reaction and Hph, confering hygromycin B resistance, was used as a selective marker. The complementation strain was created by introducing a 4.4-kb fragment containing the wild-type copy of snf1 into Δsnf1. Genomic DNA was used as a template in the amplification of snf1 by the high-fidelity PCR amplification. Total DNA from each strain was extracted from mycelium grown in 200mL PLB (0.1% lactose to replace of dextrose in PDB) for 4 days, as described by Hao et al. [19]. PCR amplification and Southern blotting were performed to characterize the disruption of snf1 in Δsnf1 strain and in the complementation strain snf1-C [23].
2.3. Analysis of snf1 Roles on Carbon Source Utilization
To determine the effects of alternative carbon source utilization on mycelium growth, equal numbers of conidia (~5 × 104) from NK17, Δsnf1 and the complementation strain snf1-C were placed separately on a YNB (0.17% YNB, 0.5% (NH4)2SO4) supplemented with 2% glucose, 2% sucrose, 2% glycerol, 2% xylose, 2% fructose, 2% maltose and 2% galactose, individually. The plates were then incubated at 28 °C. Three plates were set for each type of sugar.
2.4. Quantification of Conidia Production and Mycelia
Conidia were collected from cultures inoculated on PDA at 28 °C for 7 days. The plates were washed twice with sterile distilled water and the concentration of conidia suspension in sterile distilled water was determined by hemocytometer. Total mycelium was isolated from cultures inoculated in PDB, at 28 °C, for 2, 3, 4, 5, 6, 8 and 10 days, respectively. Fresh mycelium was isolated by vacuum filtration and dry mycelium was obtained by vacuum freeze-drying. The weight of the dry mycelium was determined. Triplicates were set in each treatment.
2.5. Heat Tolerance Assay
To test the effect of snf1 on heat tolerance, fresh conidia and mycelium were harvested from cultures inoculated on PDA at 28 °C for six days, or in PDB at 28 °C for three days (P. microspora can undergo sporulation readily in liquid culture). Conidia and mycelium were washed with sterile ddH2O (double distilled water). Fresh conidia and mycelium were then incubated at 45 °C in water bath for 2 h. Equal numbers of conidia (~5 × 104) or equal volume of mycelium was inoculated on PDA at 28 °C for 168 h. Conidia without heat-shocked served as control. Assays were conducted in triplicates.
2.6. Phenotype Observation and Secondary Metabolite Profiling for Δsnf1
Equal numbers of conidia (~5 × 104) from NK17, Δsnf1 and the complement strain snf1-C were inoculated into PDB, or onto PDA plates, respectively, for monitoring phenotypic variation. Each assay was set in triplicate.
To analyze the secondary metabolites, equal numbers of conidia (~5 × 105) from different strains were cultured in 200 mL PDB (in 500-mL flask), 28 °C, with shaking at 180 rpm for 168 h. Mycelium and the liquid phase were separated by centrifugation (Sigma 2-16 KL, Sigma Laborzentrifugen GmbH, Germany) followed by vacuum filtration onto 3M filter paper. The culture supernatant was extracted with an equal volume of ethyl acetate. The organic phase was transferred for evaporation to yield a concentrated residue, which was suspended in 1 mL of methanol. Samples in 20 μL of methanol were injected for high performance liquid chromatography (HPLC) analysis. The device used was the CoM HPLC system (CoMetro Technology, South Plainfeld, NJ, USA). It was conducted at 30 °C, using a C-18 ODS column (4.6 × 250 mm) (Plainfeld) and eluted with methanol/H2O. The flow rate was 1 mL/min. The solvent gradient for HPLC was: Solvent A (95% methanol in H2O, v/v) and solvent B (70% methanol in H2O, v/v). The chromatographic data were collected and analyzed digitally using the Agilent EZChrom Elite software (Agilent Technologies, Santa Clara, CA, USA). Yield was determined three times in parallel and variations were calculated as a standard error. Cultured in flasks could reflect vegetative growth and conidiation in liquid culture.
2.7. Drug and Stress Sensitivity Assays
For drug and stress sensitivity assays, 5 × 104 conidia from NK17, Δsnf1 and snf1-C were incubated on PDA plates supplemented separately with 0.02% Congo red, 0.8 M KCl, 1 M NaCl, 1 M sorbitol, 2 mM H2O2, 50 μg/mL G418, 300 ng/mL caspofungin and 50 ng/mL calcofluor white. All cultures were incubated at 28 °C for seven days, in triplicate.
3. Results
3.1. Characterization of snf1 Homolog in Pestalotiopsis microspora
The genome of P. microspora NK17 has been sequenced (unpublished data). When searching using the amino acid sequence of Snf1 from Saccharomyces cerevisiae as the query, only one homologous protein was found in P. microspora NK17 (38.27% identity and designated as snf1, GenBank accession no. MG462730). An open reading frame (ORF) of snf1 in P. microspora NK17 was predicted to be 2544 bp in length, encoding a peptide of 745 amino acids (Figure 1a). Structural analysis of Snf1 suggested that this protein contains a catalytic kinase domain (KD) (residues 64-318) and a C-terminal domain (CTD) (563-745 residues). Amino acid sequence alignment of KD (74.12% identity and CTD (25.13% identity) indicated that Snf1 shared high identity with Snf1 homologs in S. cerevisiae (Figure 1a). The high similarity among these sequences suggests a conserved function of Snf1 in P. microspora.

Figure 1.
Identification and deletion of snf1 in Pestalotiopsis microspora NK17. (a) Schematic diagram of the structure of Snf1 protein from P. microspora NK17 and amino-acid sequence (partial sequence) alignments of Snf1 homologs from Saccharomyces cerevisiae. Numbers indicate the length and the location of the conserved domain of the protein, including kinase domain (KD) and C-terminal domain (CTD). The overall percentage of amino acid sequence identity with ScSnf1 is shown on the right. The identical amino acids are starred and highlighted in blue and the less conserved amino acids are shown in turquoise; (b) The disruption cassette on the vector pOSCAR-URA-Snf1 carried the homologous fragments of snf1. Bottom panel showed the polymerase chain reaction (PCR) verification of the deletion in the mutants. Two fragments, 3.9 kb and 2.8 kb, were obtained by PCR amplification for Δsnf1, while no band was seen for NK17; (c) The left panel, the wild-type copy that was reintroduced in the deleted strain Δsnf1 was shown. And the probe used in Southern blotting (the right panel) was highlighted in red. Southern blot was shown on the right to confirm the deletion of snf1. Genomic DNAs from NK17, Δsnf1 and the complementation strain snf1-C were digested with Spe I and Xba I. The probe used for Southern blotting was amplified by primers Snf1-up (F) and Snf1-down (R). Two bands on the membrane, at 0.4 and 3.8 kb, were obtained for Δsnf1, while in wild-type (WT) NK17, one band of 2.7 kb was observed. In the complementation strain snf1-C, there were three bands (0.4, 2.7 and 3.8 kb).
To investigate the role of snf1 in P. microspora NK17, we made a targeted disruption mutant for snf1 via homologous recombination. The disruption cassette was described in detail in the Materials and Methods section. The open reading frame (ORF) of Snf1 was replaced by the selection marker (ura3 gene) (Figure 1b). Three transformants were confirmed as anticipated by PCR amplification and Southern blotting (Figure 1b,c). The transformant No.3 was used for further study. The complementation strain was obtained by way of a procedure described in the Materials and Methods section and verified by Southern blotting (Figure 1c).
3.2. Snf1 Is Necessary for Conidiation, Colonial Pigmentation and Vegetative Growth
As yeast Snf1 did not show significant effect on vegetative growth, we first tested whether P. microspora NK17 snf1 has a similar role. We cultivated the fungal strains NK17, Δsnf1 and the complement snf1-C on PDA and in PDB. We found that the growth and conidiation of Δsnf1 decreased remarkably (Figure 2a). The subsequent detection of conidiation and growth curve (based on dry weight of mycelia) also confirmed this phenomenon (Figure 2b,c).
Figure 2.
Phenotype of Δsnf1. (a) Difference in pigmentation and growth rate between the wild type (WT) or the complement strain snf1-C and Δsnf1. Strains were grown either on PDA or in PDB; (b) The number of conidia produced by NK17, Δsnf1 and the complement strain snf1-C was determined as 5.74 ± 0.35 × 106 (p < 0.01), 0.87 ± 0.15 × 106 (p < 0.01) and 5.74 ± 0.35 × 106 (p < 0.01), per plate, respectively. Each strain was incubated at 28 °C for 168 h. Error bars represent standard deviation; (c) A growth curve based on the quantity of dry-weight of mycelia for NK17, Δsnf1 and the complementation strain snf1-C in PDB at the indicated time points. Dry weight was obtained as the mean value of three parallel cultures. Fungal strains were incubated at 28 °C.
Disruption of snf1 led to dramatically decreased production of conidia on PDA (Figure 2b). The mutant strain Δsnf1 produced an average of 0.87 ± 0.15 × 106 (p < 0.01) conidia per plate, whereas NK17 produced about 5.74 ± 0.35 × 106 (p < 0.01) conidia per plate and the complement strain snf1-C restored the number of conidia to 5.93 ± 0.32 × 106 (p < 0.01) conidia per plate. Furthermore, compared to NK17, Δsnf1 produced much less mycelium and exhibited lighter colonies (Figure 2a,c). Thus, snf1 plays a critical role in conidiation, mycelial pigmentation and vegetative growth in P. microspora NK17.
3.3. Requirement of snf1 for Utilization of Carbon Sources
Previous studies have established that yeast snf1 gene is a key regulator in the utilization of secondary carbon sources under glucose-limiting condition. To examine whether P. microspora NK17 snf1 played this canonical role, we tested the growth of Δsnf1 on galactose, sucrose, glycerol, xylose, fructose and maltose as sole carbon source (Figure 3a). In contrast to the wild type, Δsnf1 exhibited apparently reduced growth rate on all above carbon sources, in particular, on xylose, fructose, sucrose and galactose. This phenomenon confirmed the classic role of P. microspora Snf1 has in the baker’s yeast in sucrose utilization (it was originally named for Sucrose-Non-Fermenting). On the other hand, disruption of snf1 led to dramatically decrease in conidia production on all the carbon sources (Figure 3b). As we have shown, unlike in the baker’s yeast, P. microspora snf1 was also needed for the utilization of glucose (Figure 2a), thus, we conclude that Snf1 plays a critical role in the regulation of general carbon metabolism in P. microspora.
Figure 3.
Effect of snf1 on the use of alternative carbon sources. (a) Changes of conidiation/pigmentation and vegetative growth were observed in Δsnf1 comparing to the wild-type (WT) and the complement strains. The conidiation (indicated by pigmentation) and vegetative growth of Δsnf1 decreased obviously on sucrose, xylose, fructose, maltose and galactose, while the change was less dramatic on glycerol; (b) Numbers of conidia produced by NK17, Δsnf1 and the complement strain snf1-C was determined in the carbon sources as indicated. Triplicate PDA plates for each strain were incubated at 28 °C for 168 h. Error bars represent standard deviations.
3.4. Roles of Snf1 in Tolerance to External Stress
S. cerevisiae Snf1 plays an important role in stress resistance. To test the role of NK17 snf1 in response to stress conditions, assays were performed in the presence of the following chemical reagents at appropriate concentrations: cell wall inhibitors Congo red, calcofluor white and caspofungin; osmotic reagents KCl and NaCl; oxidant H2O2; osmotic stabilizer sorbitol; and the antifungal drug G418. In order to verify whether the deletion of snf1 affected the integrity of the cell wall, we respectively tested the sensitivity of the mutant strain to three cell wall inhibitors in the medium. As shown in Figure 4a, addition of 0.02% Congo red to PDA plates resulted in profound growth inhibition of Δsnf1 compared to the controls. Likewise, 50 ng/mL calcofluor white and 300 ng/mL caspofungin also remarkably inhibited the growth of the mutant, while the wild-type and the complement strains underwent a normal growth (Figure 4a, bottom panels). This data clearly demonstrated that cell wall integrity was disrupted in the mutant strain Δsnf1. Treatment with high concentrations of salts 0.8 M KCl, 1 M NaCl and 1 M sorbitol, could dramatically inhibit vegetative growth of the mutant strain (Figure 4b), comparing to the control strains (bottom plates in Figure 4b). This result suggests that the cellular responses in NK17 to osmotic pressure requires the function of snf1. On plates supplemented with 2 mM oxidant H2O2, Δsnf1 obviously showed a slower growth, implying a role of snf1 in tolerance to this stress condition (Figure 4b). Lastly, the mutant strain Δsnf1 exhibited a hypersensitivity to 50 μg/mL G418 (Figure 4b). Moreover, disruption of snf1 also had a significant impact on conidiation in external stress (Figure 4c).
Figure 4.
Susceptibility tests for Δsnf1 to adverse culture conditions. (a) Stress tolerance to cell wall inhibitors, Congo red, calcofluor white and caspofungin on PDA. PDA without the supplements served as the control. Conidiation and vegetative growth of Δsnf1 was significantly affected; (b) Stress tolerance to osmotic pressure generated by high concentration of KCl, NaCl and sorbitol. Growth test under oxidative stress (2 mM H2O2), plus G418 Susceptibility tests for Δsnf1; (c) The number of conidia produced by NK17, Δsnf1 and the complementation strain snf1-C was determined in the indicated conditions and triplicate PDAs for each strain were incubated at 28 °C for 168 h. Error bars represent standard deviations.
3.5. Sensitivity of Δsnf1 to Heat Shock
We tested the growth of Δsnf1 under heat shock to see whether the gene played any role in this process. The result was shown in Figure 5. As shown, the mutant showed a profound growth defect comparing to the wild-type and the complemented strain (Figure 5a). Moreover, the mutant showed a dramatically decrease in conidiation (Figure 5b). It was indicated that P. microspora NK17 Snf1 played a crucial role in heat shock. Interestingly, the mutant spores were more sensitive than the mutant mycelium under incubation at 45 °C for 2 h.
Figure 5.
Sensitivity of Δsnf1 to heat shock. (a) Fresh spores and mycelium were incubated in sterile ddH2O at 45 °C for 2 h. Equal numbers of conidia (~5 × 104) or equal volume of mycelium from NK17, Δsnf1 and the complementation strain snf1-C were inoculated on PDA at 28 °C for seven days. Δsnf1 showed a high sensitivity to heat shock. Conidia without heat-shocked served as control; (b) The number of conidia produced by NK17, Δsnf1 and the complementation strain snf1-C was determined in every medium and triplicate PDA plates for each strain were incubated at 28 °C for 168 h and used for quantification. Error bars represent standard deviations.
3.6. Roles of Snf1 in the Biosynthesis of Secondary Metabolites
Regulation of the biosynthesis of secondary metabolites is complex in filamentous fungi and is usually intimately coordinated with fungal development [24]. To examine the role of Snf1 in biosynthesis of secondary metabolites in P. microspora NK17, we examined the profile of secondary compounds in Δsnf1 cultures by HPLC. We found that deletion of snf1 obviously altered the profile of secondary metabolites (Figure 6a). Based on HPLC profiling, peaks of most secondary metabolites in Δsnf1 were substantially lower than that of the wild type. Interestingly, the polyketide pestalotiollide B [24] that we described before was considerably reduced in the mutant strain Δsnf1 (Figure 6a). Most significantly, when strains were cultured in galactose as sole carbon source, the general production of secondary metabolites in Δsnf1, including pestalotiollide B, was almost inhibited (Figure 6b). The production of secondary metabolites was restored to nearly the wild-type level and pattern in the profile of the complement strain (Figure 6b, bottom panel). Above data showed that Δsnf1 lead to a decrease in mycelium production (Figure 2c), whether it was the determinant of PB change. The ratio of peak area of PB peak relative to the dry weight of mycelium was analyzed (Figure 6c). The result suggested that snf1 had effects on the production of PB. The above results demonstrate that snf1 is a regulator of secondary metabolism and may be involved in either activation or silencing of certain gene clusters in NK17.

Figure 6.
High performance liquid chromatography (HPLC) profiling for secondary metabolites in Δsnf1. (a) HPLC profiling of the secondary metabolites in Δsnf1 cultured in PDB. The peak patterns including pestalotiollide B peak of Δsnf1 was distinct from that of the wild type; (b) HPLC profiling of the secondary metabolites in Δsnf1 in galactose as sole carbon source. HPLC profiling analysis was repeated for three times; (c) The ratio of peak area of PB peak relative to the dry weight of mycelium was analyzed. The relative yield of PB in Δsnf1 significantly decreased comparing with wild-type, especially in the medium of galactose. Error bars represent standard deviations.
4. Discussion
The Snf1/AMPK is highly conserved among eukaryotic organisms and is an important regulator in carbon metabolism and in energy homeostasis. Many studies have established that Snf1 concerts carbon metabolism by sensing glucose limitation. In S. cerevisiae, SNF1 acts as an activator for more than 400 glucose-repressing genes and some of them are involved in alternative carbon source utilization [25]. Also, other regulatory functions of Snf1 involve in the response to various environmental stress. In this study, we firstly demonstrated Snf1 of P. microspora played a comparable role in the utilization of alternative carbon sources. For instance, it is required for the use of sucrose (Figure 2 and Figure 3). However, distinct from the baker’s yeast snf1, our data suggest that P. microspora snf1 took part in the utilization of glucose, as disruption of snf1 showed a significant delay in growth on PDA plate under permissive condition (Figure 2). This result suggests a complexity of carbon metabolism in fungus [26].
Nonetheless, our observation suggests that snf1 in P. microspora shares similar roles in several other aspects, e.g., in stress response. We found that P. microspora snf1 was involved in heat tolerance (Figure 5). This function of snf1 homologs was previously reported in another yeast fungus Cryptococcus neoformans [27]. In our fungus, either the spores or the mycelium of the mutant Δsnf1 was shown to be sensitive to 45 °C heat-shock (Figure 5a). Another important finding is that snf1 is essential for the cell wall biosynthesis in this filamentous fungus. By challenging the mutant strain Δsnf1 with the wall inhibitors, the dyes Calcofluor white and Congo, we demonstrated that the growth of the mutant strain was substantially inhibited (Figure 4a). A similar result was obtained for the drug caspofungin which is a chemotherapeutic chemical targeting fungal cell wall biosynthesis. The dyes Calcofluor white and Congo red, which target the biosynthesis of (1, 3) β-glucans and chitin during cell growth and protoplast wall generation, have been used in test of fungal wall integrity [28,29]. Taking into account of this result, we speculated that sensitivity of the mutant strain Δsnf1 to heat shock might be resulted from the impairment of the cell wall integrity. In addition, previous studies in S. cerevisiae have shown that the heat shock transcription factor (HSF) is a target of Snf1 in response to glucose limitation but not to heat shock [30]. Whether HSF is the target of Snf1 is not clear in P. microspora.
Our data suggest that snf1 is required for conidiation in the filamentous fungus P. microspora (Figure 2b and Figure 3b). Disruption of snf1 in NK17 led to dramatic decrease in conidia production. Although there has been considerable progress in the genetic regulation and light effect on conidiation [31,32], the molecular mechanisms regulating asexual sporulation are still not fully understood in filamentous fungi. Evidence from other study support this view. For example, disruption of PdSNF1, a snf1 homology, also resulted in impaired conidiation and caused malformation of the conidiophore structures in Penicillium digitatum [33] and the germination and nucleation of both ascospores and conidia were delayed in GzSNF1 mutants [34]. Taken together, these data suggest that snf1 may have a role in concerting the carbon metabolism and conidia development in filamentous fungi, though the underlying mechanism remains to be identified.
Many filamentous fungi have the capacity to produce a myriad of secondary metabolites. It is still puzzling in many fungi how the synthesis of secondary metabolites is modulated with fungal differentiation and growth, especially with the formation of conidia [24,33]. Fungal secondary metabolism is reportedly regulated by mitogen-activated protein kinase (MAPK) pathway [35], G-protein/cAMP/PKA pathway [36] and velvet complex pathway [32,37]. In this study, we found a possible regulatory role of snf1 in the production of secondary metabolites. Through HPLC profiling for Δsnf1, it was revealed that snf1 participates in the regulation of the biosynthesis of a polyketide metabolite pestalotiollide B (Figure 6a). Besides, the general pattern of the peaks for products declined sharply in the HPLC profile in the mutant strain Δsnf1 compared to the wild type and the complement strain. Therefore, this result suggests that Snf1 likely plays a positive regulation in the biosynthesis of these metabolites including pestalotiollide B (PB) (Figure 6c). Notably, in the complement strain, production of PB seems to be restored to the wild-type level. However, this strain displayed a different secondary production profile from the wild type (Figure 6c). This is perhaps caused by the ectopic insertion of the reintroduced copy of snf1, which affect the way of its expression. Still more, when the strains were grown in galactose as the sole carbon source, deletion of snf1 almost abolished the biosynthesis of secondary metabolites (Figure 6b). The above results clearly suggest that snf1 can function as a critical global regulator controlling secondary metabolism.
5. Conclusions
Our work identified and characterized a SNF1/AMPK homolog in the taxol-producing fungus Pestalotiopsis microspora. Snf1 plays a critical role in the regulation of the stress response, alternative carbon source utilization and thermotolerance. Importantly, Snf1 is a key regulator in the growth, development and the biosynthesis of secondary metabolites of filamentous fungi.
Acknowledgments
This work was financially supported by the National Science Foundation of China (#31470251), the National High Technology Research and Development Program (“863” Program #2012AA022105), a grant from the Fundamental Research Funds for the Central Universities (2015NT10), and an Open Fund of the Key Laboratory of Cell Proliferation and Regulation Biology, Ministry of Education.
Author Contributions
X.Z. conceived and designed the experiments, and the writing and correction of the manuscript; Da.W. and Y.L. performed most of the experiments, repeated them side by side. H.W. conducted bioinformatics; Do.W. constructed the vectors for the laboratory. X.H. participated in analysis of the data and polished the first draft; B.X. contributed reagents and materials; O.A. and Y.L. conducted the HPLC profiling separately. Da.W. and X.H. prepared the first draft of the paper.
Conflicts of Interest
The authors declare no conflict of interest.
References
- Ghillebert, R.; Swinnen, E.; Wen, J.; Vandesteene, L.; Ramon, M.; Norga, K.; Rolland, F.; Winderickx, J. The AMPK/SNF1/SnRK1 fuel gauge and energy regulator: Structure, function and regulation. FEBS J. 2011, 278, 3978–3990. [Google Scholar] [CrossRef] [PubMed]
- Hardie, D.G. AMP-activated/SNF1 protein kinases: Conserved guardians of cellular energy. Nat. Rev. Mol. Cell Biol. 2007, 8, 774–785. [Google Scholar] [CrossRef] [PubMed]
- Hedbacker, K.; Hong, S.P.; Carlson, M. Pak1 protein kinase regulates activation and nuclear localization of Snf1-Gal83 protein kinase. Mol. Cell. Biol. 2004, 24, 8255–8263. [Google Scholar] [CrossRef] [PubMed]
- Kim, M.D.; Hong, S.P.; Carlson, M. Role of Tos3, a Snf1 protein kinase kinase, during growth of Saccharomyces cerevisiae on nonfermentable carbon sources. Eukaryot. Cell 2005, 4, 861–866. [Google Scholar] [CrossRef] [PubMed]
- Nath, N.; McCartney, R.R.; Schmidt, M.C. Yeast Pak1 kinase associates with and activates Snf1. Mol. Cell. Biol. 2003, 23, 3909–3917. [Google Scholar] [CrossRef] [PubMed]
- Sutherland, C.M.; Hawley, S.A.; McCartney, R.R.; Leech, A.; Stark, M.J.R.; Schmidt, M.C.; Hardie, D.G. Elm1p is one of three upstream kinases for the Saccharomyces cerevisiae SNF1 complex. Curr. Biol. 2003, 13, 1299–1305. [Google Scholar] [CrossRef]
- Hong, S.P.; Leiper, F.C.; Woods, A.; Carling, D.; Carlson, M. Activation of yeast Snf1 and mammalian AMP-activated protein kinase by upstream kinases. Proc. Natl. Acad. Sci. USA 2003, 100, 8839–8843. [Google Scholar] [CrossRef] [PubMed]
- Sanz, P.; Alms, A.G.; Haystead, T.A.; Carlson, M. Regulatory interactions between the Reg1-Glc7 protein phosphatase and the Snf1 protein kinase. Mol. Cell. Biol. 2000, 20, 1321–1328. [Google Scholar] [CrossRef] [PubMed]
- Cannon, J.F.; Pringle, J.R.; Fiechter, A.; Khalil, M. Characterization of glycogen-deficient glc mutants of Saccharomyces cerevisiae. Genetics 1994, 136, 485–503. [Google Scholar] [PubMed]
- Huang, D.; Wilson, W.A.; Roach, P.J. Glucose-6-P control of glycogen synthase phosphorylation in yeast. J. Biol. Chem. 1997, 272, 22495–22501. [Google Scholar] [CrossRef] [PubMed]
- Thompson-Jaeger, S.; François, J.; Gaughran, J.P.; Tatchell, K. Deletion of Snf1 affects the nutrient response of yeast and resembles mutations which activate the adenylate cyclase pathway. Genetics 1991, 129, 697–706. [Google Scholar] [PubMed]
- Tamai, K.T.; Liu, X.; Silar, P.; Sosinowski, T.; Thiele, D.J. Heat shock transcription factor activates yeast metallothionein gene expression in response to heat and glucose starvation via distinct signalling pathways. Mol. Cell. Biol. 1994, 14, 8155–8165. [Google Scholar] [CrossRef] [PubMed]
- Bertram, P.G.; Choi, J.H.; Carvalho, J.; Chan, T.F.; Ai, W.; Zheng, X.F.S. Convergence of TOR-Nitrogen and Snf1-Glucose Signaling Pathways onto Gln3. Mol. Cell. Biol. 2002, 22, 1246–1252. [Google Scholar] [CrossRef] [PubMed]
- De Wever, V.; Reiter, W.; Ballarini, A.; Ammerer, G.; Brocard, C. A dual role for PP1 in shaping the Msn2-dependent transcriptional response to glucose starvation. EMBO J. 2005, 24, 4115–4123. [Google Scholar] [CrossRef] [PubMed]
- Mayordomo, I.; Estruch, F.; Sanz, P. Convergence of the target of rapamycin and the Snf1 protein kinase pathways in the regulation of the subcellular localization of Msn2, a transcriptional activator of STRE (Stress Response Element)-regulated genes. J. Biol. Chem. 2002, 277, 35650–35656. [Google Scholar] [CrossRef] [PubMed]
- Hedbacker, K.; Carlson, M. SNF1/AMPK pathways in yeast. Front. Biosci. 2008, 13, 2408–2420. [Google Scholar] [CrossRef] [PubMed]
- Hardie, D.G. AMPK and SNF1: Snuffing out stress. Cell Metab. 2007, 6, 339–340. [Google Scholar] [CrossRef] [PubMed]
- Bi, J.N.; Ji, Y.; Pan, J.; Yu, Y.; Chen, H.; Zhu, X. A new taxol-producing fungus (Pestalotiopsis malicola) and evidence for taxol as a transient product in the culture. Afr. J. Biotechnol. 2011, 10, 6647–6654. [Google Scholar]
- Hao, X.R.; Ji, Y.; Liu, S.R.; Bi, J.N.; Bi, Q.; Pan, J.; Zhu, X. Optimized integration of T-DNA in the taxol-producing fungus Pestalotiopsis malicola. Afr. J. Biotechnol. 2012, 11, 771–776. [Google Scholar]
- Niu, X.; Hao, X.; Hong, Z.; Chen, L.; Yu, X.; Zhu, X. A putative histone deacetylase modulates the biosynthesis of Pestalotiollide B and conidiation in Pestalotiopsis microspora. J. Microbiol. Biotechnol. 2015, 25, 579–588. [Google Scholar] [CrossRef] [PubMed]
- Wang, D.; Akhberdi, O.; Hao, X.; Yu, X.; Chen, L.; Liu, Y.; Zhu, X. Amino acid sensor kinase Gcn2 is required for conidiation, secondary metabolism, and cell wall integrity in the taxol-producer Pestalotiopsis microspora. Front. Microbiol. 2017, 8, 1879. [Google Scholar] [CrossRef] [PubMed]
- Chen, L.; Wei, D.; Zhang, Q.; Yu, X.; Wang, Y.; Zhu, X. Orotidine 5′-phosphate decarboxylase-based reusable in situ genetic editing system: Development and application in taxol-producing Pestalotiopsis microspora. Eng. Life Sci. 2015, 15, 542–549. [Google Scholar] [CrossRef]
- Chen, L.; Li, Y.; Zhang, Q.; Wang, D.; Akhberdi, O.; Wei, D.; Pan, J.; Zhu, X. Improved pestalotiollide B production by deleting competing polyketide synthase genes in Pestalotiopsis microspora. J. Ind. Microbiol. Biotechnol. 2017, 44, 237–246. [Google Scholar] [CrossRef] [PubMed]
- Calvo, A.M.; Wilson, R.A.; Bok, J.W.; Keller, N.P. Relationship between secondary metabolism and fungal development. Microbiol. Mol. Biol. Rev. 2002, 66, 447–459. [Google Scholar] [CrossRef] [PubMed]
- Young, E.T.; Dombek, K.M.; Tachibana, C.; Ideker, T. Multiple pathways are co-regulated by the protein kinase Snf1 and the transcription factors Adr1 and Cat8. J. Biol. Chem. 2003, 278, 26146–26158. [Google Scholar] [CrossRef] [PubMed]
- Yi, M.; Park, J.H.; Ahn, J.H.; Lee, Y.H. MoSNF1 regulates sporulation and pathogenicity in the rice blast fungus Magnaporthe oryzae. Fungal Genet. Biol. 2008, 45, 1172–1181. [Google Scholar] [CrossRef] [PubMed]
- Yang, J.; Li, D.; Liu, X.; Pan, J.; Yan, B.; Zhu, X. Regulation of virulence factors, carbon utilization and virulence by SNF1 in Cryptococcus neoformans JEC21 and divergent actions of SNF1 between cryptococcal strains. Fungal Genet. Biol. 2010, 47, 994–1000. [Google Scholar] [CrossRef] [PubMed]
- Lipke, P.N.; Ovalle, R. Cell wall architecture in yeast: New structure and new challenges. J. Bacteriol. 1998, 180, 3735–3740. [Google Scholar] [PubMed]
- Ram, A.F.; Klis, F.M. Identification of fungal cell wall mutants using susceptibility assays based on Calcofluor white and Congo red. Nat. Protoc. 2006, 1, 2253–2256. [Google Scholar] [CrossRef] [PubMed]
- Hahn, J.S.; Thiele, D.J. Activation of the Saccharomyces cerevisiae heat shock transcription factor under glucose starvation conditions by Snf1 protein kinase. J. Biol. Chem. 2004, 279, 5169–5176. [Google Scholar] [CrossRef] [PubMed]
- Park, H.S.; Yu, J.H. Genetic control of asexual sporulation in filamentous fungi. Curr. Opin. Microbiol. 2012, 15, 669–677. [Google Scholar] [CrossRef] [PubMed]
- Kato, N.; Brooks, W.; Calvo, A.M. The expression of sterigmatocystin and penicillin genes in Aspergillus nidulans is controlled by veA, a gene required for sexual development. Eukaryot. Cell 2003, 2, 1178–1186. [Google Scholar] [CrossRef] [PubMed]
- Zhang, T.; Sun, X.; Xu, Q.; Zhu, C.; Li, Q.; Li, H. PdSNF1, a sucrose non-fermenting protein kinase gene, is required for Penicillium digitatum conidiation and virulence. Appl. Microbiol. Biotechnol. 2013, 97, 5433–5445. [Google Scholar] [CrossRef] [PubMed]
- Lee, S.H.; Lee, J.; Lee, S.; Park, E.H.; Kim, K.W.; Kim, M.D.; Yun, S.H.; Lee, Y.W. GzSNF1 is required for normal sexual and asexual development in the ascomycete Gibberella zeae. Eukaryot. Cell 2009, 8, 116–127. [Google Scholar] [CrossRef] [PubMed]
- Izumitsu, K.; Yoshimi, A.; Kubo, D.; Morita, A.; Saitoh, Y.; Tanaka, C. The MAPKK kinase ChSte11 regulates sexual/asexual development, melanization, pathogenicity, and adaptation to oxidative stress in Cochliobolus heterostrophus. Curr. Genet. 2009, 55, 439–448. [Google Scholar] [CrossRef] [PubMed]
- Jain, S.; Akiyama, K.; Kan, T.; Ohguchi, T.; Takata, R. The G protein β subunit FGB1 regulates development and pathogenicity in Fusarium oxysporum. Curr. Genet. 2003, 43, 79–86. [Google Scholar] [PubMed]
- Bayram, O.; Braus, G.H. Coordination of secondary metabolism and development in fungi: The velvet family of regulatory proteins. FEMS Microbiol. Rev. 2012, 36, 1–24. [Google Scholar] [CrossRef] [PubMed]
© 2018 by the authors. Licensee MDPI, Basel, Switzerland. This article is an open access article distributed under the terms and conditions of the Creative Commons Attribution (CC BY) license (http://creativecommons.org/licenses/by/4.0/).